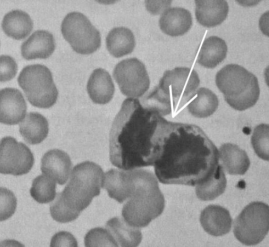

Questões de Biologia - Divisão celular (mitose e meiose, e suas fases)
Limpar pesquisa
Questão: 1 de 67
407251
Banca: FUNIVERSA
Órgão: IFB
Cargo(s): Técnico de Laboratório - Biologia
Ano: 2012
Matéria/Assunto: Biologia > Citologia / Núcleo / Divisão celular (mitose e meiose, e suas fases)
intérfase
prófase
anáfase
metáfase
telófase
Questão: 2 de 67
384858
Banca: Inst. AOCP
Órgão: SEDUC/PB
Cargo(s): Biologia
Ano: 2019
Matéria/Assunto: Biologia > Citologia / Núcleo / Divisão celular (mitose e meiose, e suas fases)
Da metáfase para a anáfase da mitose.
Da prófase I para a metáfase I da meiose I.
Da metáfase I para a anáfase I da meiose I.
Da prófase para a metáfase da mitose.
Questão: 3 de 67
333402
Banca: CESPE / Cebraspe
Órgão: SEDUC/CE
Cargo(s): Professor - Biologia / Ciências Biológicas
Ano: 2013
Matéria/Assunto: Biologia > Citologia / Núcleo / Divisão celular (mitose e meiose, e suas fases)
os cromossomos duplicados apresentam seu maior grau de condensação.
as cromátides-irmãs são visíveis e estão mantidas unidas pelo quiasma.
as fibras do fuso estão separando os cromossomos homólogos.
os cromossomos homólogos estão pareados.
as cromátides-irmãs estão sofrendo disjunção.
Questão: 4 de 67
297357
Banca: CESPE / Cebraspe
Órgão: IF/RJ - Fluminense
Cargo(s): Professor - Biologia / Ciências Biológicas
Ano: 2018
Matéria/Assunto: Biologia > Citologia / Núcleo / Divisão celular (mitose e meiose, e suas fases)
anáfase.
telófase.
metáfase.
prófase I.
prófase mitótica.
Questão: 5 de 67
267050
Banca: CESPE / Cebraspe
Órgão: PF
Cargo(s): Policial Federal - Papiloscopista
Ano: 2018
Matéria/Assunto: Biologia > Citologia / Núcleo / Divisão celular (mitose e meiose, e suas fases)
Internet: <https://laminoteca.wixsite.com>.
A imagem anterior foi obtida a partir de amostras de sangue
coletadas em uma cena de crime para fins de isolamento de DNA.
Várias células foram observadas, mas uma delas (indicada
pela seta) apresentava um aspecto morfológico diferenciado.
Com base nessa imagem, julgue o item seguinte.